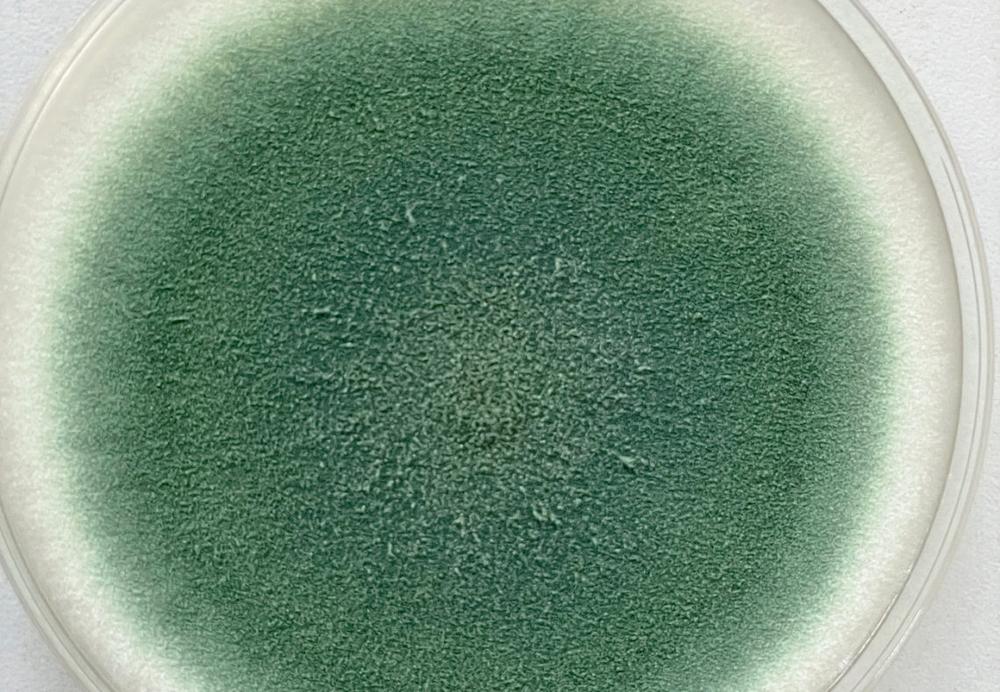
Lietuvos mokslininkai tiria mikroskopinių grybų paslaptis ir naudą | Lietuvos agrarinių mokslų ir miškų centro Žemdirbystės instituto nuotr.

Mokslininkai visame pasaulyje ieško būdų, kaip natūraliomis priemonėmis pagerinti dirvožemį, padidinti derlių ir tuo pačiu kuo mažiau kenkti aplinkai.
Lietuvos mokslininkai taip pat nesnaudžia – jau ketverius metus gamina mikroskopinių grybų gaminį, skirtą apipurkšti po derliaus nuėmimo laukuose liekančias augalines liekanas.
Grybai jas suskaido, praturtina dirvožemį maisto medžiagomis, sulaiko jame anglį ir taip mažina anglies dvideginio patekimą į atmosferą.
Lietuvos agrarinių mokslų ir miškų centro Žemdirbystės institute mokslininkai ketverius metus atlieka tyrimus su mikroskopiniais grybais skaidytojais.
Jie tiria, kaip mikroskopiniai grybai keičia dirvožemio kokybinius parametrus augalininkystės plotuose.
Tyrimų rezultatai džiugina
Biotechnologijų mokslininkas Stanislavas Balionas (Stanislav Balion) pasakoja, kad Lietuvoje gamina mikroorganizmų gaminius, padedančius įsisavinti maistines medžiagas dirvožemyje, kovojančius su įvairiais augalų ligų sukėlėjais ir gaminančius organinę dirvožemio dalį – humusą.
„Rezultatai rodo, kad mikroskopiniai grybai veiksmingai skaido šiaudus. Per ketverius metus tiriamame lauke humuso kiekis išaugo nuo pradinio 1,5 proc. iki 1,79 proc.
Tai labai teigiamas pokytis, o ūkininkai žino humuso reikšmę. Didėjant humusui gerėja ir kiti rodikliai: dirvoje geriau išlaikoma drėgmė, gerėja deguonies apykaita.
Taip pat tiriame ir maisto medžiagas dirvožemyje. Jau pirmaisiais tyrimo metais tiriamame lauke mineralinio azoto buvo 25 proc. daugiau nei tokiame pat lauke, tręšiamame azoto trąšomis, taip pat fosforo ir kalio vidutiniškai kasmet randama 22 proc. daugiau“, – pasakoja mokslininkas.
Jo su bendraminčiais mokslininkais įkurtas startuolis „Bioversio“ rūpinasi, kad ūkininkai tinkamai apdorotų augalines liekanas.
„Ūkininkai dažnai augalinių liekanų visai neapdoroja, nes mano, kad nereikia, arba naudoja azoto trąšas, bakterinius gaminius ar kitas priemones.
Problema tokia, kad tuo metu nedominuoja gerieji grybai skaidytojai ir maisto medžiagos neišsaugomos, gerokai mažiau kaupiama anglis“, – pastebi įmonės „Bioversio“ direktorius S. Balionas.
Pasak jo, naujausi mokslininkų tyrimai rodo, kad mikroskopiniai grybai gali padėti išspręsti šią daugeliui ūkininkų kylančią problemą.

Kas yra mikroskopiniai grybai?
Grybai priskiriami atskirai karalystei. Jie nėra nei augalai, nei gyvūnai, bet turi ir vienų, ir kitų rūšių požymių.
Manoma, kad grybai galėjo būti pirmaisiais gyviais Žemėje, o jų rūšių skaičiuojama nuo 2,2 iki 3,8 milijono ir tik maža dalis jų yra ištirta.
Mikroskopinių grybų galima rasti visur – jie gali gyventi žmogaus kūne, gali sunaikinti didžiausius pastatus ar didžiausius laukus pasėlių.
Grybai yra pirminiai negyvų audinių apdorotojai gamtoje, nes tik jie gali tinkamai suskaidyti liekanas, kad maisto medžiagos išliktų ir išsisaugotų anglis.
Mikroskopiniai grybai reguliuoja dirvožemio dujų apykaitą, vandens režimą ir temperatūros svyravimus, apsaugo dirvos paviršių nuo išdžiuvimo, suvartoja augalų šaknų išskirtas toksines medžiagas.
„Mikroskopiniai grybai vaidina esminį vaidmenį negyvų augalų skaidymo procesuose, nes jie vieninteliai turi mechanizmą skaidyti ligniną, celiuliozę ir hemiceliuliozę – audinius, kurie yra pagrindinė sudedamoji augalų ląstelių sienelių dalis.
Ligninas ir celiuliozė yra labai tvirti junginiai, mediena tokia kieta ir yra dėl ląstelių sienelėse esančio lignino. Tam, kad jau iš negyvo augalo ląstelių maisto medžiagos dirvožemyje išliktų, pirmiausia reikia suskaidyti ląstelių sieneles. Tai gamtoje geba daryti tik mikroskopiniai grybai“, – pasakoja mokslininkas.
Grybai, pasak jo, skaidydami negyvus augalus – šiaudus, ražieną ir šaknis – kaupia organinę anglį, formuojasi humusas ir taip susidaro palanki aplinka kitiems gyviams – bakterijoms ir sliekams.